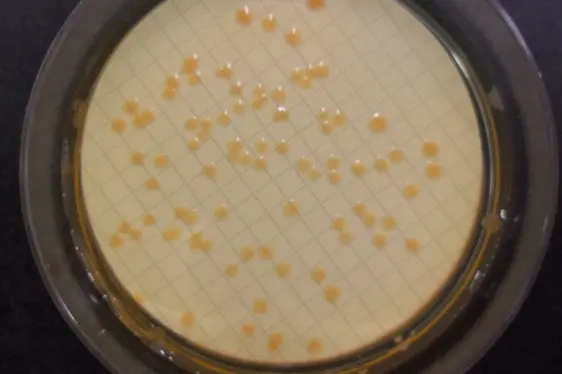
Mikrobiologische Untersuchung: Coliforme Keime im Wasser; Petrischale mit Kolonien von Coliforme-Keimen (Foto: Landesagentur für Umwelt und Klimaschutz)
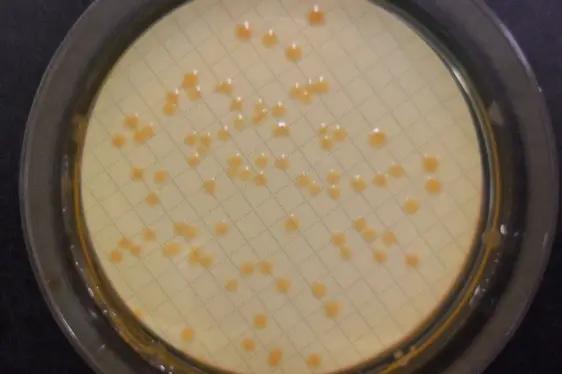
Mikrobiologische Untersuchung: Coliforme Keime im Wasser; Petrischale mit Kolonien von Coliforme-Keimen (Foto: Landesagentur für Umwelt und Klimaschutz)
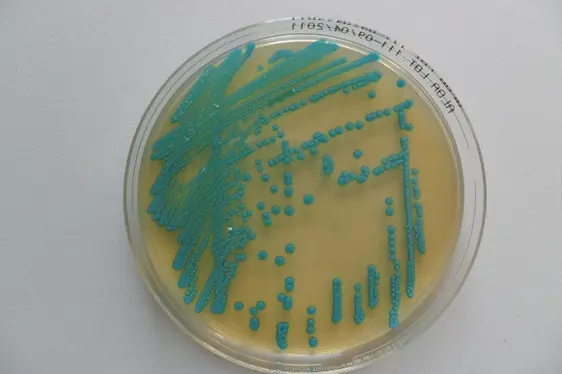
Mikrobiologische Untersuchung: Listeria in Lebensmitteln; Petrischale mit Listeria monocytogenes-Kolonien (Foto: Landesagentur für Umwelt und Klimaschutz)
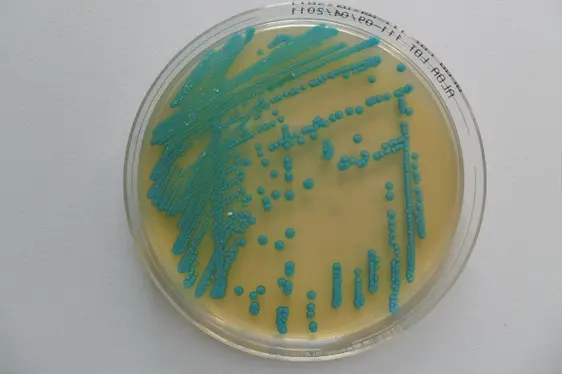
Mikrobiologische Untersuchung: Listeria in Lebensmitteln; Petrischale mit Listeria monocytogenes-Kolonien (Foto: Landesagentur für Umwelt und Klimaschutz)
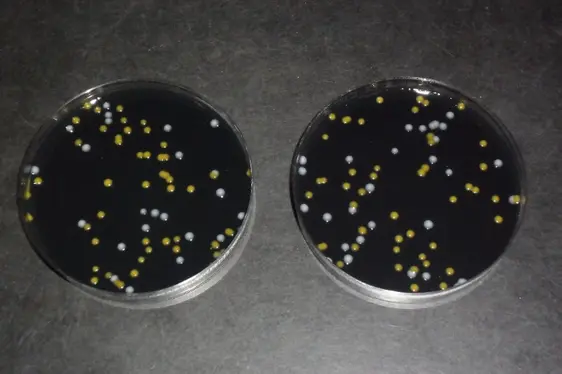
Mikrobiologische Untersuchung: Nachweis von Legionella; Petrischalen mit Legionella-Kolonien (Foto: Landesagentur für Umwelt und Klimaschutz)
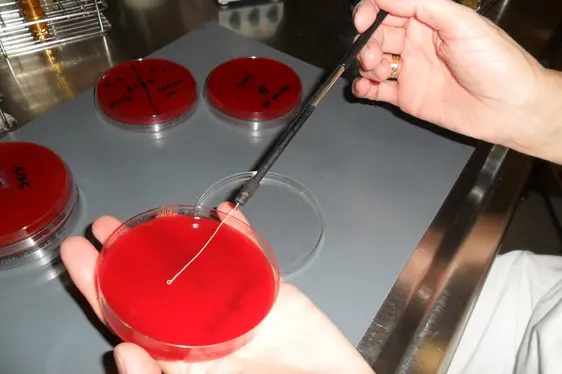
Mikrobiologische Untersuchung: Bakterienausstrich auf Nährboden (Foto: Landesagentur für Umwelt und Klimaschutz)

Akkreditierung
Die Laboratorien der Landesagentur für Umwelt sind gemäß der Norm UNI CEI EN ISO/IEC 17025 für verschiedene chemische, mikrobiologische, physikalische und molekularbiologische Prüfverfahren akkreditiert. Diese Norm definiert die Voraussetzungen, welche ein Labor erfüllen muss, um technisch fundierte und zuverlässige Analyseergebnisse zu gewährleisten. Im Zuge einer Akkreditierung überprüft die legitimierte Institution ACCREDIA das Qualitätsmanagementsystem der Laboratorien auf die Konformität mit der oben angeführten Norm und bescheinigt die technische Kompetenz des Personals. Die Laboratorien unterliegen jährlichen Kontrollen (System- und Fachaudits), welche die Einhaltung der Konformität an die Norm über die Jahre bestätigen. Die Akkreditierung ist daher eine kontinuierliche Garantie für Kompetenz und Zuverlässigkeit.
Die Akkreditierung ist nach einer entsprechenden Konvention geregelt und diese impliziert von Seiten von ACCREDIA nicht die Zustimmung zu einer Probe oder zu Analysenergebnissen oder irgendwelchen Meinungen oder Interpretationen, die davon abgeleitet werden können.
Das Markenzeichen ACCREDIA oder jeder andere Bezug zur Akkreditierung/Anerkennung darf nicht an einer Analysenprobe oder einem Produkt (oder einem Teil davon) angebracht werden oder verwendet werden, um eine Zertifizierung des Produkts anzudeuten.
Die Prüfberichte und die entsprechenden Rohdaten werden 10 Jahre lang aufbewahrt und dies unter Berücksichtigung aller Datenschutzgesetze betreffend archivierte Daten. Darauffolgend werden diese Dokumente vernichtet.
Übrig gebliebene Reste von analysierten Proben werden nicht aufbewahrt. Ebenso werden eventuelle Gegenproben (zusätzliche Aliquote) von Proben, die konform zur laufenden Gesetzgebung sind, nicht aufbewahrt, außer dem Falle, dass der Kunde im Moment der Probenahme oder bei der Analysenanfrage die Rückgabe der Probe fordert. Eventuelle Gegenproben zu Proben, die zu beanstanden sind, werden wie folgt aufbewahrt:
- ein Aliquot bleibt für mindestens 60 Tage der Herstellerfirma zur Verfügung und zwar ab dem Erhalt der Mitteilung der Anzeige, sofern es sich um abgepackte Produkte handelt;
- ein Aliquot wird für mindestens 60 Tage aufbewahrt ab dem Datum, an welchem der Betroffene die Mitteilung der Beanstandung erhält und ist für eine eventuell verlangte Revisionsanalyse bestimmt;
- ein Aliquot wird für mindestens 4 Jahre aufbewahrt und steht der Gerichtsbarkeit zur Verfügung bzw. wird bis zum Abschluss des Ermittlungsverfahrens aufbewahrt, das einem eventuell eingeleiteten Strafverfahren folgt.
Verzeichnisse der Prüfverfahren
Nachstehend finden Sie die aktuellen Verzeichnisse der von ACCREDIA akkreditierten Prüfverfahren: